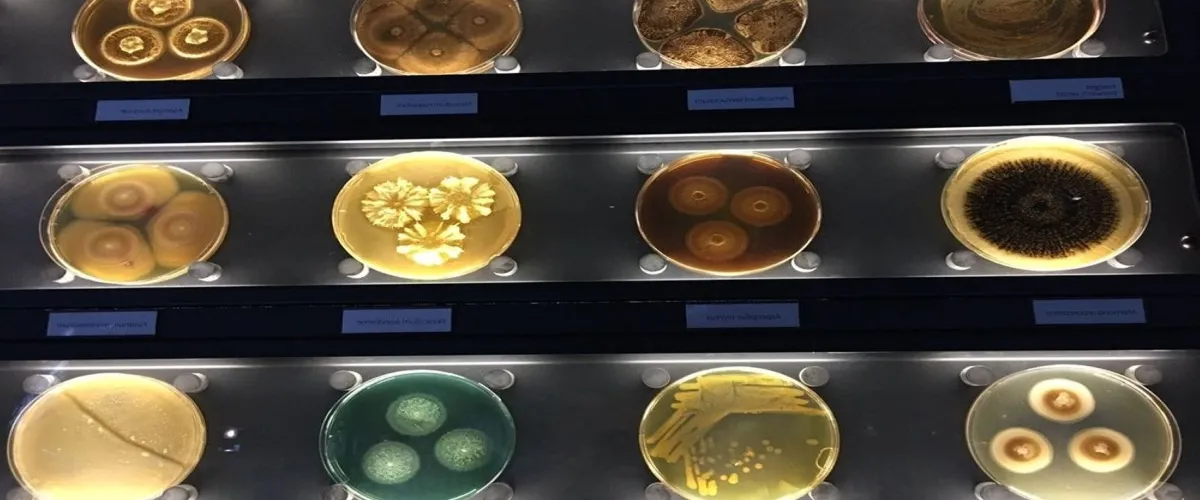

Micropia en Ámsterdam es el museo definitivo para explorar los microbios. Una visita aquí te ofrece la oportunidad de ver el mundo de una manera diferente y descubrir algo que los microorganismos tienen para ofrecerte. El museo cuenta con microscopios electrónicos, pantallas animadas, exhibiciones luminosas, conferencias rápidas, ascensores interactivos, una linda mini tienda con toallas interesantes y mucho más. La experiencia es interactiva e interesante para todos: desde niños hasta científicos. Los temas son variados e hacen justicia a la amplitud del tema. La información es comprensible e interesante para todos los niveles de conocimiento previo y siempre hay alguien del museo que puede responder cualquier pregunta. Si tienes curiosidad por la ciencia, Micropia te encantará.
1. Visita la exposición interactiva de microorganismos con una amplia variedad de formas, tamaños y colores
2. Practica el uso de microscopios profesionales para observar los microorganismos más de cerca.
3. Participa en charlas con los técnicos de laboratorio y obtén más información sobre el mundo microscópico.
4. Descubre como diversos organismos sobreviven y prosperan en diferentes climas y hábitat
1. Reúnete con tus hijos para disfrutar juntas esta experiencia única e interactiva.
2. Reserva tu entrada online con anticipación para asegurar tu lugar en la charla con el técnico de laboratorio.
3. Toma la identificación del estudiante para acceder a un descuento especial en la entrada al museo.
4. Lleva contigo efectivo o tarjetas bancarias, ya que no se aceptan cheques ni giros postales en Micropia
¿Qué hacer en Micropia? ¿por qué visitarla?
1. Visita la exposición interactiva de microorganismos con una amplia variedad de formas, tamaños y colores
2. Practica el uso de microscopios profesionales para observar los microorganismos más de cerca.
3. Participa en charlas con los técnicos de laboratorio y obtén más información sobre el mundo microscópico.
4. Descubre como diversos organismos sobreviven y prosperan en diferentes climas y hábitat
Recomendaciones:
1. Reúnete con tus hijos para disfrutar juntas esta experiencia única e interactiva.
2. Reserva tu entrada online con anticipación para asegurar tu lugar en la charla con el técnico de laboratorio.
3. Toma la identificación del estudiante para acceder a un descuento especial en la entrada al museo.
4. Lleva contigo efectivo o tarjetas bancarias, ya que no se aceptan cheques ni giros postales en Micropia